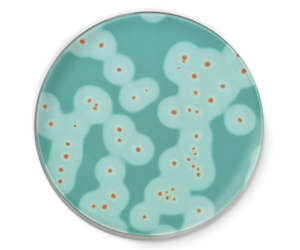
alt=

RAPID'B.cereus is the first chromogenic medium allowing the enumeration of all the pathogenic Bacillus cereus species, including Bacillus cytotoxicus, in food samples. Due to its unique sensitivity, it enables food microbiology laboratories to meet regulatory requirements for this organism.
Key Points:
- Quick response: complete results in 24 ± 3 hr
- No confirmation required
- Easy-to-read red colonies with high level of contrast: combining strong typical colony color and contrast of the halo for accurate counting
- Clear enumeration of the sensitive B. cytotoxicus
- Inhibition of background flora on raw matrices